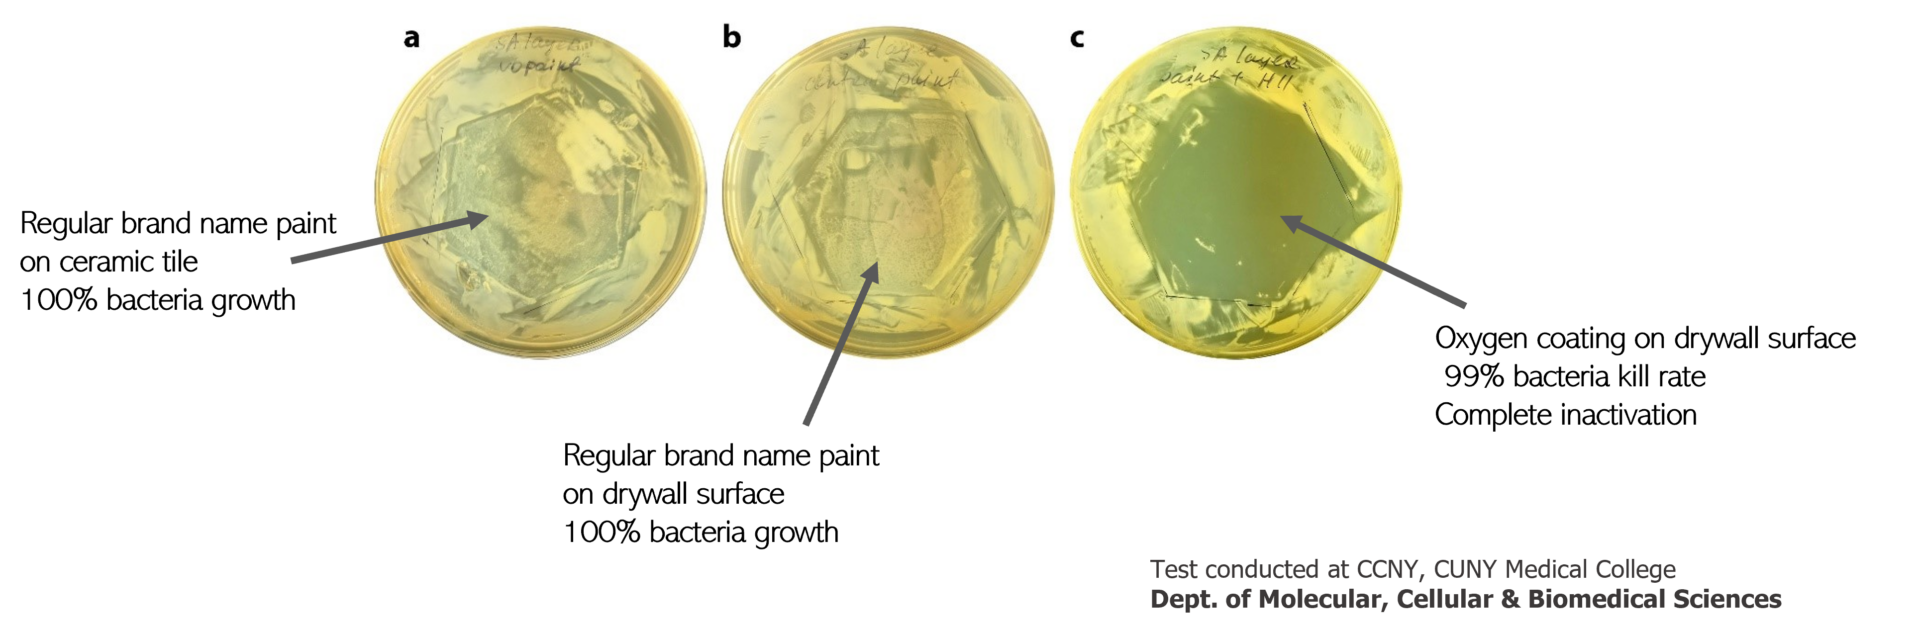

If you can’t go to the mountains every day,
let us bring the mountain AIR to YOU with Oxygen
SPECIAL OFFER

Breathe Better
Live Better
Oxygen paint additive, made with rare earth-minerals, is scientifically proven to enhance AIR freshness without requiring filters, fans, or electricity.
Just add to paint, mix and apply. It will function for upto 10 years.
★★★★
★
4.8 (1,079 reviews)
LIMITED TIME SPECIAL OFFER
$25.00
Save $2 on shipping
45 million homes in America
have DANGEROUSLY high levels of airborne contaminants
These particles are INVISIBLE to the EYE

Indoor AIR contamination is one of the top 5 causes of chronic illnesses according to the world health organization.
As more people opt to live in smaller living spaces, we are exposed to greater risk of indoor toxicity that is 5x more harmful than the outdoors.
On average, we take 22000 breathes per day which is 8 times more in volume compared to food and water.
What the experts are saying about
the importance of indoor air quality

Dr. Andrew Weil
“Indoor air has a direct impact on our cellular health and organ function. By improving the quality of air you breathe you increase your energy level and overall wellbeing.”

Dr. Ann Shippy
“The affects of toxins in the air cumulate over time affecting your cognitive function, protective skin layer and respiratory health. Improved indoor air quality leads to long term strength and vitality”.

Dr. Kalvinder Lall
“Damage from air pollution isn’t just restricted to respiratory diseases; it has been linked to systemic inflammation and oxidative stress, which can damage blood vessels and tissue, increasing the risk of chronic heart disease”.

Dr. Michael Breus
“Breathing clean and purified air while you sleep can enhance your body’s ability to repair itself overnight, leading to better sleep quality and overall wellness.”
Common symptoms of indoor contaminants
Lack of Focus & Headaches
Dizziness
& Fatigue
Eyes, Nose &
Throat Irritation
Shortness of Breath
Weight Gain &
Gut Irritation

a visible example
what biological contaminants
such as MOLD looks like on walls
with Oxygen Coating

what mold looks like on walls without Oxygen paint
A NEXT generation PAINT additive
More POWERFUL Than NATURE
Oxygen comes as a paint additive that can be mixed with ANY acrylic paint that’s commonly used for walls and ceilings.
Once mixed with paint the smart minerals will begin their photocatalytic function and start to actively neutralize harmful surface bacteria, mold and pollutants, promoting a healthier, cleaner environment.
Oxygen is Eco-friendly & made of natural minerals with EPA recognized active ingredients.
Oxygen is tested and certified by accredited US, Canadian and Global Labs using ISO 22196 protocol, a gold standard for antimicrobial surface coatings and ISO 18560 for clean air. It is also backed by a team of PhD scientists in microbiology, virology, chemistry and environmental studies.

Download the Material Data Sheet
What’s on your walls can end up in your lungs.
Conventional paint can off-gas VOCs for years. Dust, bacteria, mold spores, and pollutants cling to wall surfaces and recirculate with every breath. With Oxygen you can turn regular paint into paint with “IONIC POWERS”.
“The presence of Oxygen is the absence of disease”
Gary Brecka – Human Biologist and Biohacker
Why We Created Oxygen
Oxygen was created out of dire necessity to the founder and his wife’s personal health. Having traveled to 3 continents, 24 countries, and 40 cities, Chris Shahabi realized that his mental focus, stamina and immune system were weakening and while extensive medical tests showed no signs of immediate concern, he soon realized that his health was being compromised by the air quality he was breathing.
In 2020 when COVID struck, his wife of 27 years was hospitalized in the Intensive Care Unit for 5 days, gasping for air.
These two turn of events led him to bring a team of virologists, microbiologists, chemists and a former director of NASA JPL together to create a solution that could neutralize the negative impact of harmful pathogens, pollutants and mold before they had a chance to enter our respiratory system. This was done using scientifically proven earth minerals with ionic powers that could enhance AIR freshness, in any room, as if they were external AIR LUNGS.
“Oxygen is a scientifically engineered smart mineral-based paint additive that can actively neutralize harmful bacteria, mold and pollutants that come into contact with its coated surface.“
Chris Shahabi, founder and clean air advocate

Chris & Lidia Shahabi are Oxygens first customers
Oxygen turns regular paint into paint with IONIC powers that’s wellness-inspired

Tested by Scientists
Trusted by Health-Conscious Customers
Oxygen is a patent pending innovation that has been tested and verified for its efficacy by TOP microbiology and disease control labs in the United States and Canada, in accordance with ISO standard protocol 22196.
Click on top 2 images below to read the press releases.
How The Minerals Work
Engineered to support healthier indoor environments, Oxygen™ paint additive enhances living and work spaces because of its ingredients.
Oxygens photocatalytic air freshness function uses light energy to break down air pollutants. This process, involving earth minerals, in our case, Zinc Oxide and Silver to oxidize and decompose surface and airborne contaminants and pollutants into harmless molecules.
Here’s how Oxygen works:
Photocatalyst Activation:
The photocatalysts within Oxygen infused paint are activated by light, typically ultraviolet (UV) light.
Electron-Hole Pairs:
When light interacts with Oxygens photocatalyst minerals it generates pairs of electrons and holes.
Reactive Oxygen Species:
These electrons and holes react with oxygen, water, and surface hydroxyl groups, creating Reactive Oxygen Species (ROS).
Pollutant Degradation and Transformation to Harmless Products:
These ROS act as oxidants, breaking down air pollutants like volatile organic compounds (VOCs), bacteria, bad odor, mold and other airborne contaminants. The byproduct is fresher air.

Why use regular paint when you can
have paint with health benefits?

Applying Oxygen additive
to any acrylic PAINT is EASY
Step 1 – Buy Oxygen NOW.
Step 2 – Open 60 gram pouch and add it to a one gallon acrylic paint of choice. You can also add any pastel color if you have a preference other than white or eggshell.
Step 3 – Mix well on site for 2 to 3 minutes until it is fully dispersed before applying on a feature wall or ceiling.
Step 4 – Apply using a brush, roller or spray and leave to dry for 24 hours.
ONE SURFACE WALL or CEILING
per room is enough to help you Breathe Better AIR
within a 100 square feet radius

IDEAL MOOD & ENERGY BOOSTING colors in Pastel
We recommend using high quality, soft and earth tone WHITE paint that can be tinted within a range of colors suitable for walls and ceilings. Look for paint brands with high breathability that allows water vapor / moisture to pass through rather than being trapped within the walls. This is important because trapped moisture can lead to issues like dampness and paint failure. Oxygen additive creates some degree of breathability that helps regulate humidity allowing building walls to “breathe”.

Benefits of Breathability: By allowing moisture to escape, breathable paints help prevent:
- Dampness and Mold: Trapped moisture can create ideal conditions for mold growth, especially in older buildings or those with moisture problems.
- Paint Failure: Moisture buildup can cause paint to bubble, peel, and eventually fail.
- Damage to Building Materials: Moisture trapped within walls can damage the structure itself.
Proudly a Member of
What Customers are saying about their Oxygen experience

I have asthma and I love it that my walls now actively help me breathe better air by preventing mold growth. As someone with a respiratory health condition Oxygen has been a game changer for me.
Chacha Chapin – Puerto Vallarta, Mexico

Ever since we applied Oxygen coating in my bedroom I have been restful and waking up feeling refreshed. I feel great knowing that I am breathing higher quality air every night.
Adrian Wilk – Sarasota, Florida

The paint has an earthy texture and feels wonderful on all surfaces including my canvas artwork, that now, I have turned into air purifiers for my clients.
Anthony Pullano – Toronto, Canada

As a health conscious professional I am always looking for ways to boost my health and wellness. Oxygen coating has definitely had a visible impact on my focus and attention at home.
Rachel Lancaster – Winnipeg, Canada

I bought Oxygen for myself and for my parents who have respiratory conditions. Once we applied it on our walls we noticed a huge difference in our home within a few weeks.
Mattie Olivier – Los Angeles, California

I struggle with allergies and Oxygen coating has significantly improved the air quality in my home office where I do most of my painting projects. Now I can breathe better air quality and it feels great.
Divona Stimson – Houston, Texas

Our happy customer, Neal Livingston from Mabou, Nova Scotia, Canada painting his basement for mold protection (article click here)
Works with ALL major brands
and cleans them up




PROTECT YOURSELF NOW
Give yourself and those you care for the peace of mind you all deserve.
Buy Oxygen TODAY
With a 10 YEAR functional WARRANTY
that’s an investment of $2 a year in longevity and better respiratory health.

Oxygen Disclaimer
Oxygen Paint / Coating additive contains scientifically proven and EPA recognized active ingredients (earth minerals) that inhibit the growth and spread of bacteria, mold, and mildew in addition to its ability to minimize the impact of pollutants such as Co2 that come into contact with the painted surface film. Oxygen is not registered as a pesticide and does not in anyway shape or form claim to directly protect users against disease-causing organisms. Always clean surfaces regularly and in the event of illness consult with a physician. We do NOT make any medical claims on cures, healing, or remedy as a substitute to medicinal treatment. We recommend using Oxygen as an added precaution working seamlessly in the background in your living or work space. Buyers make the decision to purchase Oxygen paint additive on their own as a smarter alternative to regular paint with no added health and wellness benefits.







